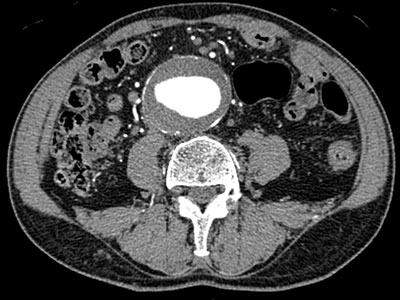

放射線診断は、X線やγ線等の放射線・電磁波・超音波等を用いて、体内あるいは疾患の様子を画像化します。
我々放射線科医は、これらを用いた最新の医療機器を最良かつ最適な方法で活用し、診療に有用な画像を提供します。また、画像を詳細に読影することにより的確な診断を行い、主治医や患者様に対して、適切な医療を行うための情報を提供します。また、放射線被ばくを伴う検査の際には、撮影範囲の適切な設定あるいは放射線量の管理等を厳密に行い、より安全かつ安心できる医療を提供することを心がけています。
当科では、X線写真、CT(Computed Tomography)、MRI(Magnetic Resonance Imaging)、RI(Radio Isotope)、US(Ultrasonography)等、複数のモダリティを用いて、放射線診断を行っています。
他の画像検査と比較して最も簡便な検査であり、被写体にX線を照射し、X線の透過性の差を白から黒の濃淡で表現した画像です。透過性の低い骨は白く描出され、透過性の高い空気は黒く描出されます。そのコントラストを評価し、正常構造や異常所見を診断しています。当院ではフィルムではなくデジタル画像が採用され、より低被ばくでの撮像が可能です。
X線を用いて、人体の輪切り画像を作成し、体内の様々な情報を得ることができます。画像データから任意断面像やカラー3次元画像、血管像などを作成することも可能です。近年の技術進歩により、短時間、高精細、低被ばくの検査が可能です。当科でも最新のDual Source CTを導入し診療を行っています。また、IVRでは、画像誘導下生検や椎体形成術等、正確な位置情報に基づいた精緻な手技にも用いられます。
造影CTおよび3D画像

拡散テンソル画像(MRI)

放射線を使用せず、磁力と電磁波を用いて体内の内部情報を画像化する検査です。1回の検査で、多数の種類の画像を撮像することができます。CTとは異なる情報が得られ、被ばくの心配はありません。一方、狭く大きな音のする空間で長時間検査を行うため、閉所恐怖症の方は検査ができない可能性があります。また、一部の患者様(体内金属、入れ墨、妊娠中の方など)は、MRIの特性上検査を受けることができない可能性があります。当院は3T(テスラ)および1.5Tの高磁場MR装置を複数台有しており、診療のみならず研究の分野においても、数多くの知見を世界に発信しています。
核医学検査では、放射線(主にγ線)を放出する放射性同位元素を含む薬剤(放射性医薬品)を体内に投与し、様々な臓器や機能を調べる検査です。CTやMRI等の形態検査とは異なり、機能画像が得られるため、脳や心臓の血流、甲状腺や副腎等の内分泌異常、悪性腫瘍の局在や活性の程度等について、調べることができます。また、当院は、RI内用療法が施行可能な県内唯一の施設であり、その治療効果判定を行う際に本検査が役立っています。
18F-FDG PET/CTなどの機能画像


超音波(人間が聞き取れない高周波数の音)を用いることで、体内をリアルタイムに観察できます。探触子(プローブ)という機械を検査部位にあて、短時間かつ苦痛を伴わずに行うことができる検査です。また、X線被ばくがなく、小児などに対しても安全に検査できます。ドップラー現象を利用すると、血流評価も可能です。また、画像誘導下での穿刺や生検等に使用できるため、IVRでも数多く利用されています。
当科は、各診療科と共にほぼ毎日カンファレンスを行っており、画像診断ならびに治療方針の決定等において重要な役割を担っています。また、放射線科内でもカンファレンスやレクチャーを毎朝行っており、画像診断に関する知識のBrush upに努めると共に、初期・後期研修医や学生に対する教育を行っています。
当科から、放射線診断専門医はもちろん、各専門領域の資格(IVR専門医、PET認定医、核医学専門医、マンモグラフィ読影認定医、第1種放射線取扱主任者など)を複数取得した、実績豊富な放射線診断専門医を数多く輩出しています。
各領域・各分野において、最新の装置を用いた画像医学の研究が盛んに行われており、本邦や海外での研究会での発表ならびに論文発表が多数あります。